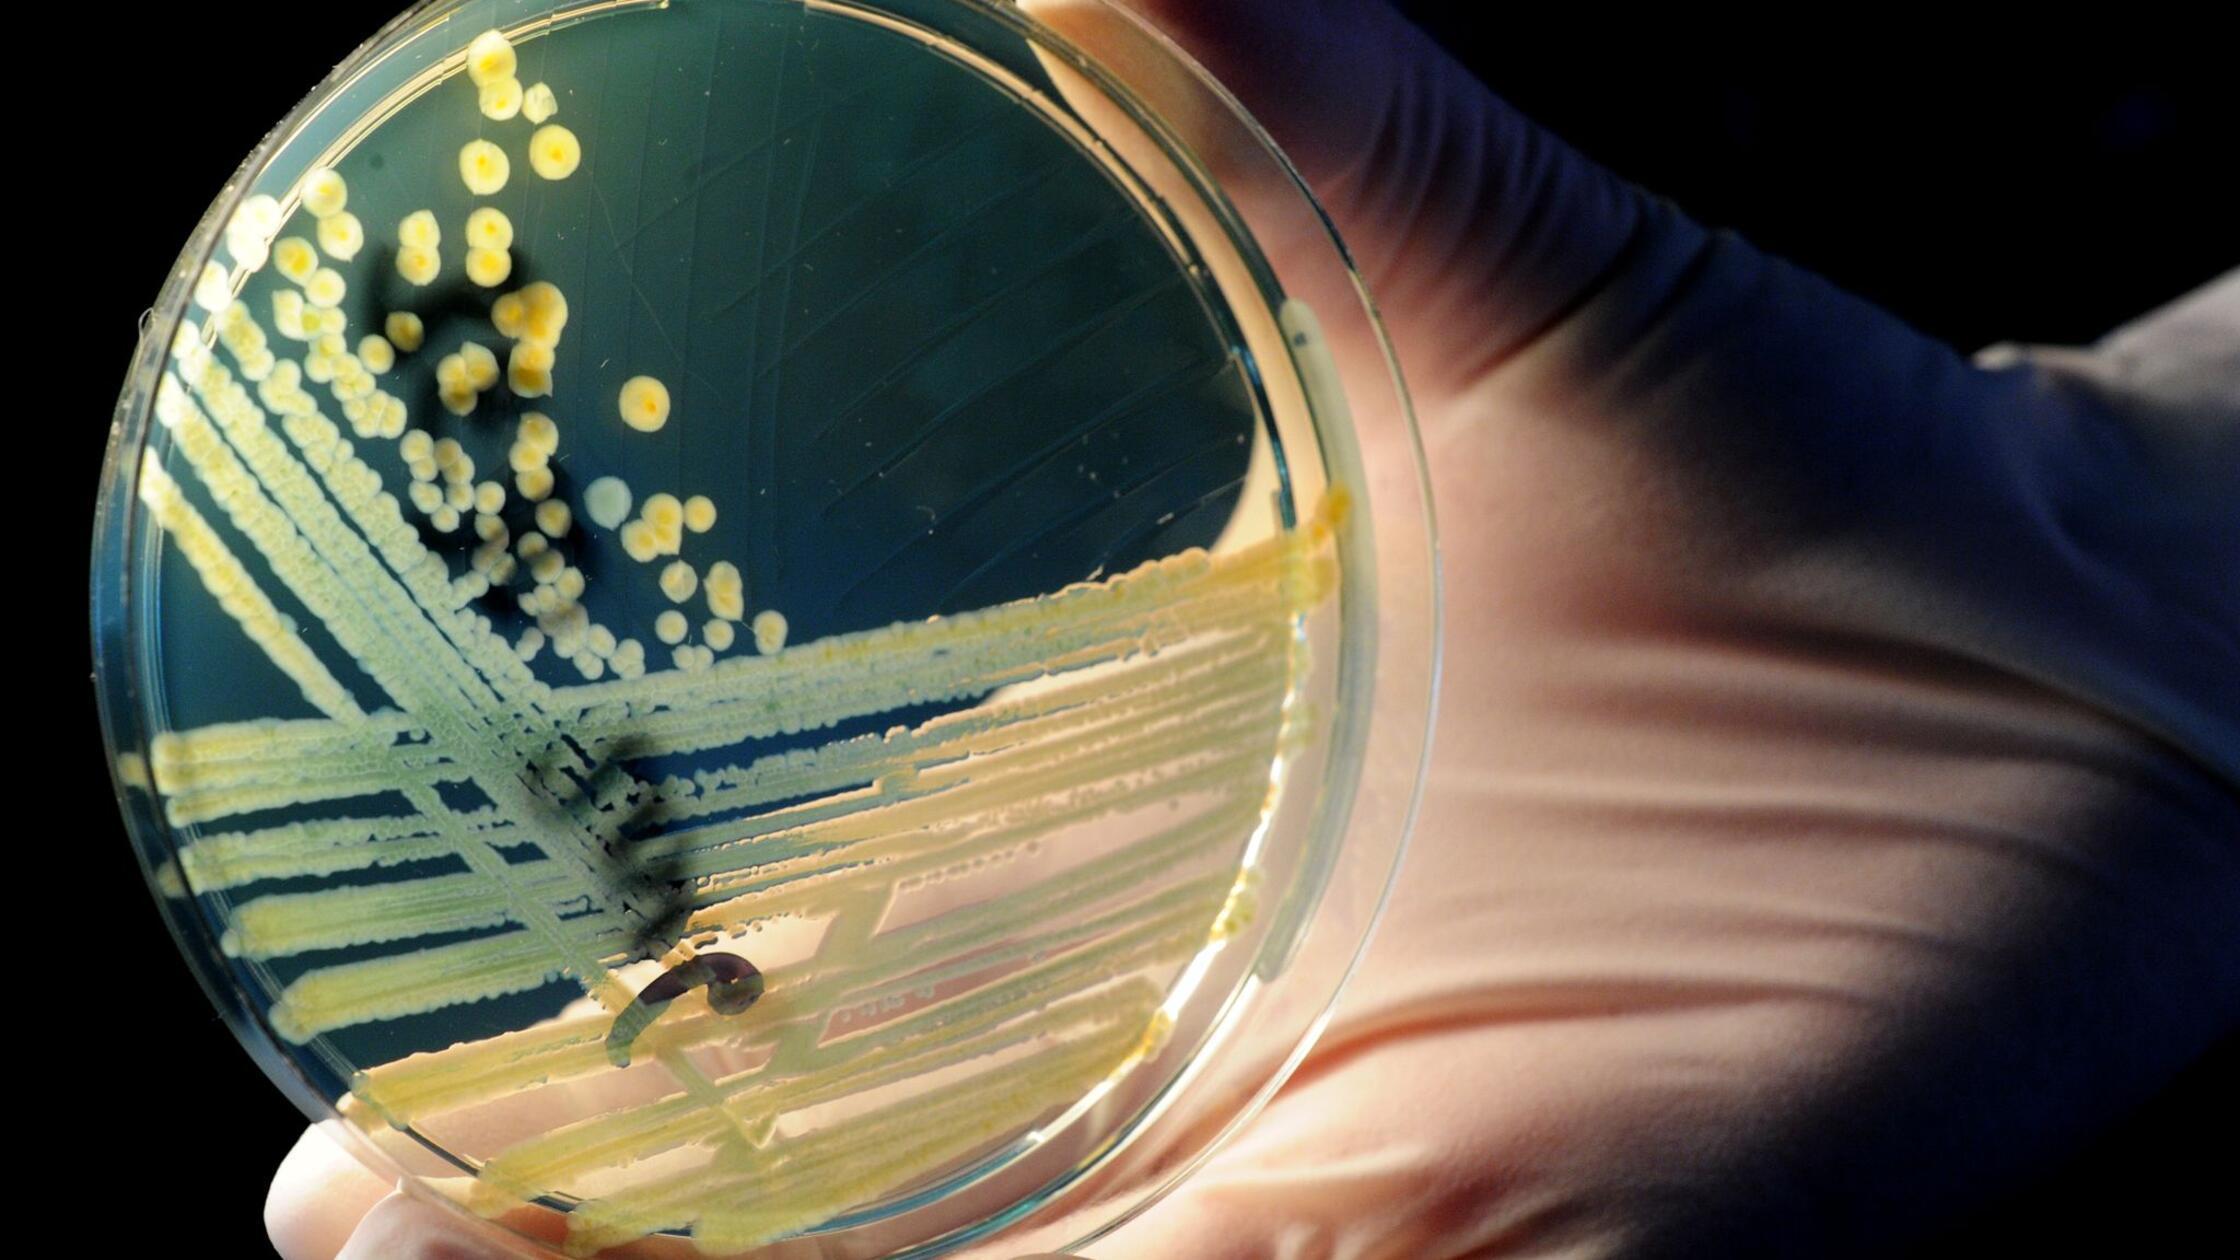
Ehec-Fälle in Vorpommern und Belgien hängen nicht zusammen

Nemec v Bambergu obsojen na enajst let zapora zaradi poskusa umora žene z zastrupitvijo
14. nov 17:05
Deželno sodišče v Bambergu je 56-letnega Nemca obsodilo na enajst let in štiri mesece zapora, ker je poskušal zastrupiti svojo ženo. Motiv za poskus umora je bila želja po novem življenju z mlajšo žensko, s katero se je spoznal preko interneta. Moški je dejanja priznal na sodišču.